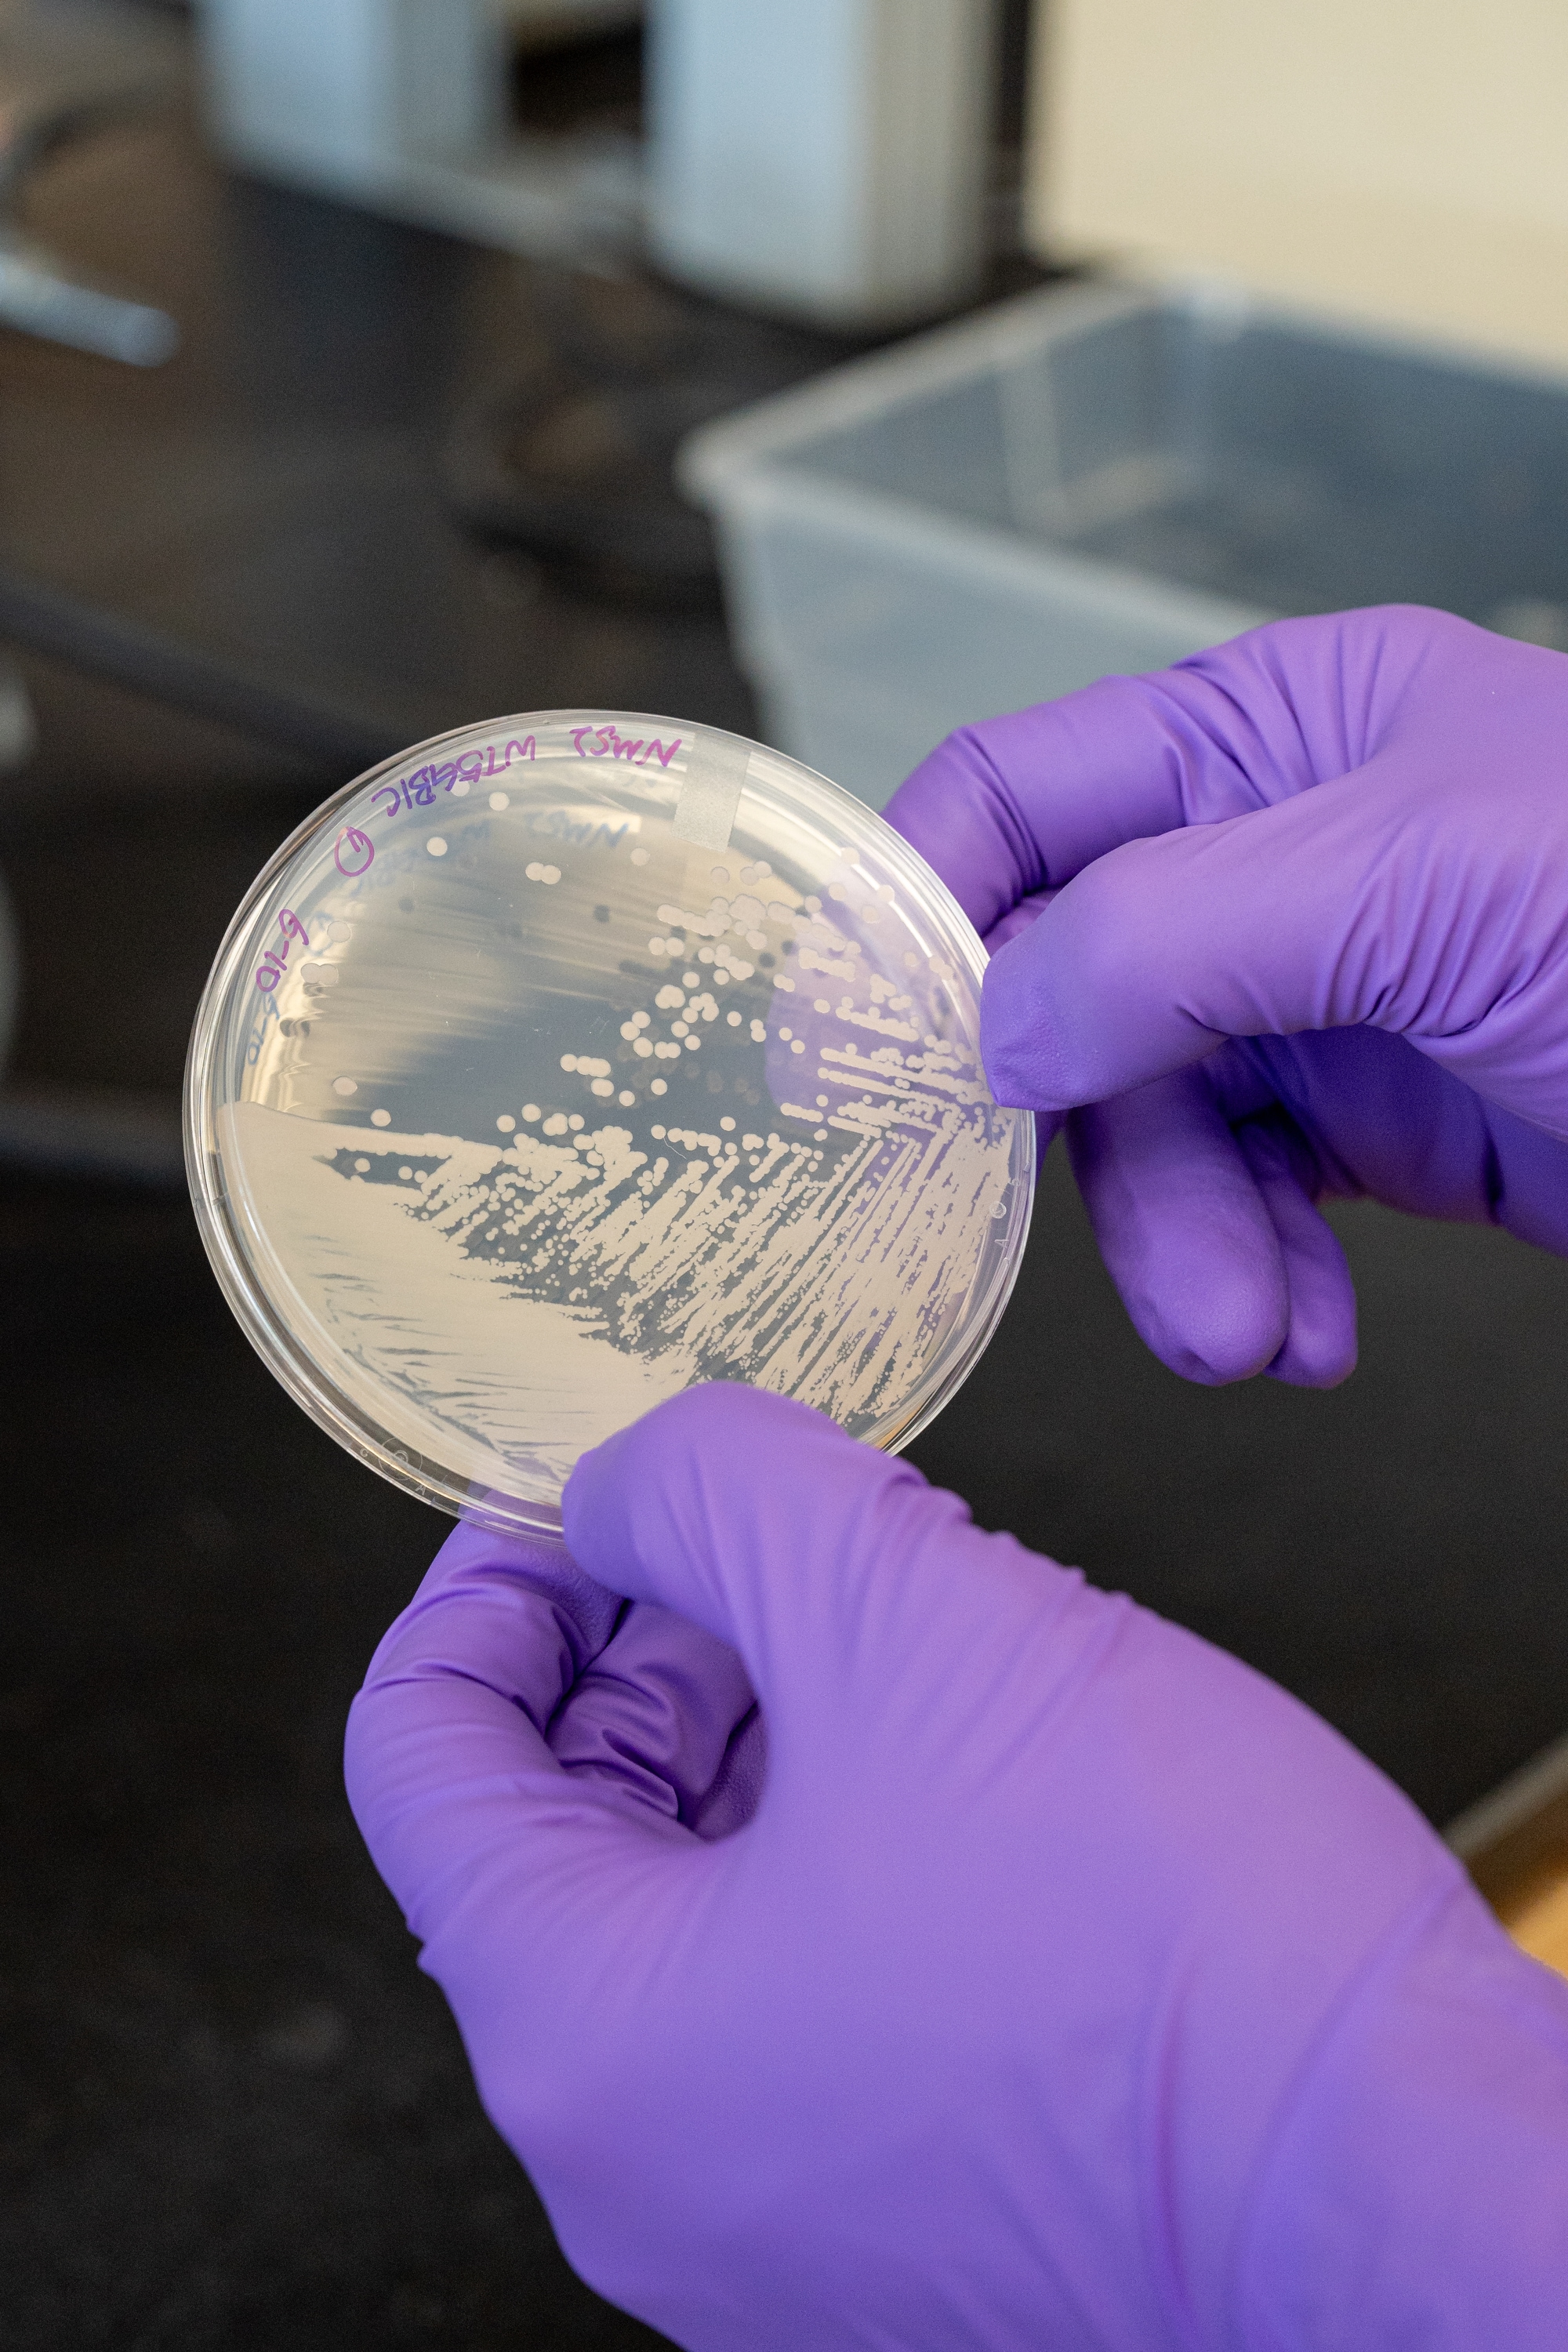

These very hungry microbes devour a powerful pollutant
PETALUMA, Calif. — The cows had to be deterred from messing with the experiment.Researchers from a Bay Area technology company had come to the sprawling dairy farm north of San Francisco to test an emerging solution to planet-warming emissions: microscopic pink organisms that eat methane, a potent greenhouse gas.Kenny Correia, 35, of Correia Family Dairy, watched the team from Windfall Bio working near the lagoons used to store manure from the farm’s several hundred cows. The researchers erected a futuristic system of vats, pipes, tubes and shiny metal supports. Then, when everything was assembled, they poured pink liquid into one of the vats. “They were looking like mad scientists out there,” Correia recounted.He acknowledged initially thinking it was a “crazy idea” to integrate an outdoor laboratory into a working farm. There was the potential for the cows to “be all over it — licking it, pulling out wires and scratching on it,” he said.But livestock farms are a significant source of methane emissions, and Windfall wanted to see how much the microbes could help.Correia Family Dairy hosted a trial of a new way to control methane emissions. (Christie Hemm Klok/For The Washington Post)Methane bubbles on a manure lagoon at the farm. (Christie Hemm Klok/For The Washington Post)Fencing around the research equipment kept the cows out. And in June, Windfall reported that the roughly month-long trial had been a success. The microbes had absorbed more than 85 percent of the methane coming from one of the lagoons.“They know how to eat methane,” said Josh Silverman, the company’s CEO and founder. “We’re not creating something new. We’re not teaching them to do something they don’t normally do. They’ve evolved for a million years to do this.”Other varieties of microbes — including the tiny organisms in the gut of cows — are among the factors implicated in the increase of methane in the atmosphere, which is warming the Earth.The gas spews from livestock farms, landfills, wastewater treatment plants, natural gas operations, oil production, rice paddies, wetlands, thawing permafrost and even termite mounds. Although methane breaks down faster than carbon dioxide, its heat-trapping potential is 80 times as powerful in the first 20 years after it’s released.Methane-eating microbes could help disrupt that process.Bottles of microbes are kept in a refrigerator at Windfall Bio. (Christie Hemm Klok/For The Washington Post)They may be especially useful if deployed at the many scattered sites responsible for small methane emissions, which can collectively add up to a big problem in the atmosphere.Windfall estimates that if its microbe technology were scaled across the energy, waste and agriculture industries in the United States, it could annually slash up to 1.6 gigatons of carbon dioxide equivalent, an amount produced by driving more than 370 million gas-powered cars for one year.Another research team, at the University of Washington, says its microbes deployed broadly could capture about 420 million metric tons of carbon dioxide equivalent per year, or what could be generated from driving nearly 98 million gas-powered cars for a year.To develop a further benefit — and to help make their enterprises more commercially viable — the researchers are working to turn the methane-eating microbes into products such as fertilizer and animal feed, supporting a more sustainable food chain.“This waste methane is a huge resource,” said Mary Lidstrom, a chemical engineer and microbiologist who is leading the UW project. “Many of the technologies that address the climate really are only addressing climate, but this has a dual outcome.” Master stocks of microbes are stored in a Windfall Bio freezer. (Christie Hemm Klok/For The Washington Post)Finding hungry microbesLidstrom’s favorite microbes come from the bottom of a lake in eastern Siberia. About 20 years ago, a Russian postdoctoral student brought a sample of Methylotuvimicrobium buryatense to the University of Washington, urging her to take a look.Lidstrom had by then been working for three decades with microbes that consume the gas, also known as methanotrophs. She’d never seen anything like this strain: The rod-shaped microbes could quickly grow in varying conditions and had an especially healthy appetite for methane — demonstrating an ability to process and use the gas for energy to reproduce even when there were only low levels in the air.It became the “workhorse” of the lab’s experiments. “It’s just better than all these other methanotrophs,” she said.The pink color is a sign of healthy microbes. (Christie Hemm Klok/For The Washington Post)Windfall Bio CEO Josh Silverman. (Christie Hemm Klok/For The Washington Post)Silverman stayed local in his search for methane-eating microbes, affectionately dubbed “mems.” From compost piles and dirt near where he lives in Palo Alto, California, he collected samples of microbes and other microorganisms that coexist with them and enable the consumption of methane in nature. “Friends and helpers,” he calls them. The samples were then incubated inside his backyard gas grill, fed by methane coming from the natural gas line.The contents of a jar labeled No. 6 emerged victorious. The “Jar 6” strain is the basis for about a dozen newer cultivations that Windfall has been experimenting with.At the company’s lab in San Mateo, California, a large refrigerator holds an assortment of jars, bottles and plastic petri dishes containing mems.“The pinker they are, usually the happier and healthier they are,” Silverman said, grabbing a small bottle about three-quarters full with a wet pink jelly.Lidstrom, who said she considers her microbes her babies, can also tell just from looking how the organisms are faring. The cells should be growing in a thick film that has the consistency of mucus, she said, and have a salmon pink hue.A hotdog roller is used to heat and mix samples in the lab. (Christie Hemm Klok/For The Washington Post)Putting microbes to the testAs researchers continue to refine and breed strains of microbes, they are trying to figure out which combinations and methods work best to eliminate methane emissions in different contexts. Manure lagoons at dairy farms, for instance, may need a different approach than landfills.The goal is to remove as much of the polluting gas as possible. Silverman said Windfall’s microbes can — in theory — eat more than 99 percent of the methane that’s released. But conditions such as outside temperature can lower that number.“From a climate perspective, zero percent of the methane is being captured currently, so any reduction at all is still a net benefit,” he said. “The fact that we could achieve such a high conversion with a cheap, small-scale, farm-viable approach fills a niche that has been historically a very tough area to crack.”There are some established ways to capture large methane emissions. Landfills, for instance, typically extract methane using a system of wells and pipes. The gas can then be processed to generate electricity or turned into renewable biogas. Substantial quantities of methane can also be flared, or burned, which turns it into carbon dioxide.But at landfills and elsewhere, some of the gas can still escape into the air. And it’s been harder to find an affordable method to contain smaller releases.The Lidstrom Lab at the University of Washington tests how much methane can be captured by microbes at a decommissioned landfill. (Jovelle Tamayo/For The Washington Post)Mary Lidstrom, a chemical engineer and microbiologist. (Jovelle Tamayo/For The Washington Post)Windfall Bio and Lidstrom’s team are both experimenting with setups that funnel waste methane into a bioreactor — a fancy word for an enclosed system that could be as simple as a plastic container — where the microbes are held. Inside these containers, the minuscule organisms consume the gas and release carbon dioxide into the air.Although it may seem odd for a climate-friendly project to release CO2, scientists say the trade-off is worth it.“I’m in favor of any approach that destroys methane, even if it makes carbon dioxide, because that’s what happens to all the methane in the atmosphere,” said Rob Jackson, a climate scientist at Stanford University’s Woods Institute for the Environment, who is not involved in the microbe projects.Over time, methane naturally breaks down into CO2. By destroying methane, “you skip the most damaging part of the molecule’s lifetime, which is the 10 or 15 years it will spend as methane in the air before it turns into carbon dioxide,” Jackson said.Windfall Bio is also looking at applying microbes directly to the land where methane is seeping from. That sort of strategy could be deployed at landfills, the third-largest source of human-related methane emissions in the U.S., according to the Environmental Protection Agency.Windfall recently ran field tests of its microbes at a major landfill near Los Angeles.“We’re looking at all the different things that we can do to reduce methane and odors from landfills, and microbiology is one of the last frontiers,” said Eugene Tseng, a technical adviser for the local California enforcement agency that oversees environmental compliance at the landfill. “The implications are huge.”The soil room at Windfall Bio, where methane and carbon dioxide is measured by a flux meter. (Christie Hemm Klok/For The Washington Post)On the day The Washington Post visited the landfill, Carla Risso, Windfall Bio’s vice president of research and development, held a large white plastic watering can full of healthy mems. She leaned over and sprinkled the light pink liquid onto a plot of soil, trying to spread the solution evenly, as a light breeze carrying the faintest whiff of trash blew the droplets around.Researchers monitored how much methane was released from various plots treated with different applications of mems. A single application absorbed more than 75 percent of methane emissions, according to a Windfall report, and the microbes consumed at that rate for more than 30 days.Lian He, a researcher at the Lidstrom Lab, after collecting data from the landfill testing site. (Jovelle Tamayo/For The Washington Post)Condensation in a bioreactor with trays of microbe cultures. (Jovelle Tamayo/For The Washington Post)In Seattle, Lidstrom’s team launched its first field test in June, using a prototype bioreactor, made by colleagues at Auburn University, to capture methane emissions seeping from a decommissioned landfill on the UW campus.By the end of several rounds of testing, Lidstrom said the bioreactor was working as well in the field as it does in laboratory settings. Under certain conditions, the system achieved up to 90 percent reduction of methane, according to peer-reviewed results published in October.Although Lidstrom said there are still improvements to be made, her long-term vision is to deploy between 100,000 to 200,000 shipping-container-size treatment units that can be used to capture and process methane. The goal, she said, is to start putting units in the field by 2030.“It’ll take some years to ramp up,” she said.Some of the herd at Correia Family Dairy. (Christie Hemm Klok/For The Washington Post)The value of wasteMethane-eating microbes are natural recyclers. As they derive energy from methane, they grow and multiply, creating biomass, an organic material packed with protein and other nutrients.Researchers are trying to capitalize on this capability — to make their work even more beneficial, attract more customers and be profitable enough to reach scale.Lindstrom wants to repurpose the biomass as a protein-rich supplement for farmed fish. She anticipates that climate change and other factors leading to the decline of wild fish populations could increase the demand for aquaculture.“There’s already a market,” she said, noting that at least one cellular agriculture company is using microbes to produce protein for pet, fish and livestock feed. “It’s already been demonstrated, you don’t have to start from scratch, and it’s of reasonable value.”Windfall has begun producing fertilizer made from mems. The microbes are dried, turned into powder and pressed into chalky brown cylindrical pellets that carry a faint odor of dried meat. The company is also looking into developing a liquid fertilizer, Silverman said.The idea is that farms that use their microbes for containing methane can get fertilizer in return, which the farmers can either use themselves or sell.“If you are asking people to pay more for a climate solution, it doesn’t happen,” he said. “We need these things to be able to pay back for the operator itself.”A young bull calf rests in a barn. (Christie Hemm Klok/For The Washington Post)Making compost out of manure, using a solid waste separator, can help reduce methane emissions. (Christie Hemm Klok/For The Washington Post)Whether there will be large-scale demand for either a protein supplement or fertilizer produced through these methods is still something of an open question.Dairy farms don’t typically need fertilizer, since they use liquid manure, said Joseph Button, vice president of sustainability and strategic impact with Straus Family Creamery. But he said he could see some of the creamery’s suppliers, like Correia, interested in selling it to other agriculture operations.“There’s been a lot of — I’ll call them ‘biological solutions’ that have popped up that have not proven out at all,” Button said. “Part of my role is to safeguard the farmers from bad solutions.”But after reviewing lab data and seeing that Windfall had secured backing from major donors, such as Amazon’s Climate Pledge Fund, Button agreed to pitch farmers in his network on hosting a microbes pilot. (Amazon founder Jeff Bezos owns The Post.)Correia Family Dairy is certified as an organic milk supplier. (Christie Hemm Klok/For The Washington Post)Correia said he would welcome more tests at his dairy farm.The farm already uses other approaches to reduce emissions, including processing solid manure into compost. But as he checked on new calves — each a source of methane — Correia said he hoped that with the right technology and methods, he could one day run a farm that has “no negative impact on the environment.”“It’s 100 percent possible,” he said.
Microscopic organisms are being deployed to capture methane from sources such as farms and landfills, with the potential for reuse as fertilizer and fish food.
PETALUMA, Calif. — The cows had to be deterred from messing with the experiment.
Researchers from a Bay Area technology company had come to the sprawling dairy farm north of San Francisco to test an emerging solution to planet-warming emissions: microscopic pink organisms that eat methane, a potent greenhouse gas.
Kenny Correia, 35, of Correia Family Dairy, watched the team from Windfall Bio working near the lagoons used to store manure from the farm’s several hundred cows. The researchers erected a futuristic system of vats, pipes, tubes and shiny metal supports. Then, when everything was assembled, they poured pink liquid into one of the vats. “They were looking like mad scientists out there,” Correia recounted.
He acknowledged initially thinking it was a “crazy idea” to integrate an outdoor laboratory into a working farm. There was the potential for the cows to “be all over it — licking it, pulling out wires and scratching on it,” he said.
But livestock farms are a significant source of methane emissions, and Windfall wanted to see how much the microbes could help.


Fencing around the research equipment kept the cows out. And in June, Windfall reported that the roughly month-long trial had been a success. The microbes had absorbed more than 85 percent of the methane coming from one of the lagoons.
“They know how to eat methane,” said Josh Silverman, the company’s CEO and founder. “We’re not creating something new. We’re not teaching them to do something they don’t normally do. They’ve evolved for a million years to do this.”
Other varieties of microbes — including the tiny organisms in the gut of cows — are among the factors implicated in the increase of methane in the atmosphere, which is warming the Earth.
The gas spews from livestock farms, landfills, wastewater treatment plants, natural gas operations, oil production, rice paddies, wetlands, thawing permafrost and even termite mounds. Although methane breaks down faster than carbon dioxide, its heat-trapping potential is 80 times as powerful in the first 20 years after it’s released.
Methane-eating microbes could help disrupt that process.

They may be especially useful if deployed at the many scattered sites responsible for small methane emissions, which can collectively add up to a big problem in the atmosphere.
Windfall estimates that if its microbe technology were scaled across the energy, waste and agriculture industries in the United States, it could annually slash up to 1.6 gigatons of carbon dioxide equivalent, an amount produced by driving more than 370 million gas-powered cars for one year.
Another research team, at the University of Washington, says its microbes deployed broadly could capture about 420 million metric tons of carbon dioxide equivalent per year, or what could be generated from driving nearly 98 million gas-powered cars for a year.
To develop a further benefit — and to help make their enterprises more commercially viable — the researchers are working to turn the methane-eating microbes into products such as fertilizer and animal feed, supporting a more sustainable food chain.
“This waste methane is a huge resource,” said Mary Lidstrom, a chemical engineer and microbiologist who is leading the UW project. “Many of the technologies that address the climate really are only addressing climate, but this has a dual outcome.”

Finding hungry microbes
Lidstrom’s favorite microbes come from the bottom of a lake in eastern Siberia. About 20 years ago, a Russian postdoctoral student brought a sample of Methylotuvimicrobium buryatense to the University of Washington, urging her to take a look.
Lidstrom had by then been working for three decades with microbes that consume the gas, also known as methanotrophs. She’d never seen anything like this strain: The rod-shaped microbes could quickly grow in varying conditions and had an especially healthy appetite for methane — demonstrating an ability to process and use the gas for energy to reproduce even when there were only low levels in the air.
It became the “workhorse” of the lab’s experiments. “It’s just better than all these other methanotrophs,” she said.


Silverman stayed local in his search for methane-eating microbes, affectionately dubbed “mems.” From compost piles and dirt near where he lives in Palo Alto, California, he collected samples of microbes and other microorganisms that coexist with them and enable the consumption of methane in nature. “Friends and helpers,” he calls them. The samples were then incubated inside his backyard gas grill, fed by methane coming from the natural gas line.
The contents of a jar labeled No. 6 emerged victorious. The “Jar 6” strain is the basis for about a dozen newer cultivations that Windfall has been experimenting with.
At the company’s lab in San Mateo, California, a large refrigerator holds an assortment of jars, bottles and plastic petri dishes containing mems.
“The pinker they are, usually the happier and healthier they are,” Silverman said, grabbing a small bottle about three-quarters full with a wet pink jelly.
Lidstrom, who said she considers her microbes her babies, can also tell just from looking how the organisms are faring. The cells should be growing in a thick film that has the consistency of mucus, she said, and have a salmon pink hue.

Putting microbes to the test
As researchers continue to refine and breed strains of microbes, they are trying to figure out which combinations and methods work best to eliminate methane emissions in different contexts. Manure lagoons at dairy farms, for instance, may need a different approach than landfills.
The goal is to remove as much of the polluting gas as possible. Silverman said Windfall’s microbes can — in theory — eat more than 99 percent of the methane that’s released. But conditions such as outside temperature can lower that number.
“From a climate perspective, zero percent of the methane is being captured currently, so any reduction at all is still a net benefit,” he said. “The fact that we could achieve such a high conversion with a cheap, small-scale, farm-viable approach fills a niche that has been historically a very tough area to crack.”
There are some established ways to capture large methane emissions. Landfills, for instance, typically extract methane using a system of wells and pipes. The gas can then be processed to generate electricity or turned into renewable biogas. Substantial quantities of methane can also be flared, or burned, which turns it into carbon dioxide.
But at landfills and elsewhere, some of the gas can still escape into the air. And it’s been harder to find an affordable method to contain smaller releases.

Windfall Bio and Lidstrom’s team are both experimenting with setups that funnel waste methane into a bioreactor — a fancy word for an enclosed system that could be as simple as a plastic container — where the microbes are held. Inside these containers, the minuscule organisms consume the gas and release carbon dioxide into the air.
Although it may seem odd for a climate-friendly project to release CO2, scientists say the trade-off is worth it.
“I’m in favor of any approach that destroys methane, even if it makes carbon dioxide, because that’s what happens to all the methane in the atmosphere,” said Rob Jackson, a climate scientist at Stanford University’s Woods Institute for the Environment, who is not involved in the microbe projects.
Over time, methane naturally breaks down into CO2. By destroying methane, “you skip the most damaging part of the molecule’s lifetime, which is the 10 or 15 years it will spend as methane in the air before it turns into carbon dioxide,” Jackson said.
Windfall Bio is also looking at applying microbes directly to the land where methane is seeping from. That sort of strategy could be deployed at landfills, the third-largest source of human-related methane emissions in the U.S., according to the Environmental Protection Agency.
Windfall recently ran field tests of its microbes at a major landfill near Los Angeles.
“We’re looking at all the different things that we can do to reduce methane and odors from landfills, and microbiology is one of the last frontiers,” said Eugene Tseng, a technical adviser for the local California enforcement agency that oversees environmental compliance at the landfill. “The implications are huge.”

On the day The Washington Post visited the landfill, Carla Risso, Windfall Bio’s vice president of research and development, held a large white plastic watering can full of healthy mems. She leaned over and sprinkled the light pink liquid onto a plot of soil, trying to spread the solution evenly, as a light breeze carrying the faintest whiff of trash blew the droplets around.
Researchers monitored how much methane was released from various plots treated with different applications of mems. A single application absorbed more than 75 percent of methane emissions, according to a Windfall report, and the microbes consumed at that rate for more than 30 days.


In Seattle, Lidstrom’s team launched its first field test in June, using a prototype bioreactor, made by colleagues at Auburn University, to capture methane emissions seeping from a decommissioned landfill on the UW campus.
By the end of several rounds of testing, Lidstrom said the bioreactor was working as well in the field as it does in laboratory settings. Under certain conditions, the system achieved up to 90 percent reduction of methane, according to peer-reviewed results published in October.
Although Lidstrom said there are still improvements to be made, her long-term vision is to deploy between 100,000 to 200,000 shipping-container-size treatment units that can be used to capture and process methane. The goal, she said, is to start putting units in the field by 2030.
“It’ll take some years to ramp up,” she said.

The value of waste
Methane-eating microbes are natural recyclers. As they derive energy from methane, they grow and multiply, creating biomass, an organic material packed with protein and other nutrients.
Researchers are trying to capitalize on this capability — to make their work even more beneficial, attract more customers and be profitable enough to reach scale.
Lindstrom wants to repurpose the biomass as a protein-rich supplement for farmed fish. She anticipates that climate change and other factors leading to the decline of wild fish populations could increase the demand for aquaculture.
“There’s already a market,” she said, noting that at least one cellular agriculture company is using microbes to produce protein for pet, fish and livestock feed. “It’s already been demonstrated, you don’t have to start from scratch, and it’s of reasonable value.”
Windfall has begun producing fertilizer made from mems. The microbes are dried, turned into powder and pressed into chalky brown cylindrical pellets that carry a faint odor of dried meat. The company is also looking into developing a liquid fertilizer, Silverman said.
The idea is that farms that use their microbes for containing methane can get fertilizer in return, which the farmers can either use themselves or sell.
“If you are asking people to pay more for a climate solution, it doesn’t happen,” he said. “We need these things to be able to pay back for the operator itself.”


Whether there will be large-scale demand for either a protein supplement or fertilizer produced through these methods is still something of an open question.
Dairy farms don’t typically need fertilizer, since they use liquid manure, said Joseph Button, vice president of sustainability and strategic impact with Straus Family Creamery. But he said he could see some of the creamery’s suppliers, like Correia, interested in selling it to other agriculture operations.
“There’s been a lot of — I’ll call them ‘biological solutions’ that have popped up that have not proven out at all,” Button said. “Part of my role is to safeguard the farmers from bad solutions.”
But after reviewing lab data and seeing that Windfall had secured backing from major donors, such as Amazon’s Climate Pledge Fund, Button agreed to pitch farmers in his network on hosting a microbes pilot. (Amazon founder Jeff Bezos owns The Post.)

Correia said he would welcome more tests at his dairy farm.
The farm already uses other approaches to reduce emissions, including processing solid manure into compost. But as he checked on new calves — each a source of methane — Correia said he hoped that with the right technology and methods, he could one day run a farm that has “no negative impact on the environment.”
“It’s 100 percent possible,” he said.
